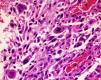

Pure renal sarcomas are rare; sometimes they are related to the renal capsule or blood vessels and a few cases of osteosarcoma have been reported. We report an unusual case of renal osteosarcoma in an 80-year-old man who underwent nephrectomy for pyelo-ureteral stenosis and hydronephrosis. The tumor was hemorrhagic and attached to the pyelocaliceal surface. Histopathology revealed a pleomorphic neoplasm with features of telangiectatic osteosarcoma. No areas of transitional or renal cell carcinoma or other sarcomatous component were present. Relevant features, such as calcifications and osseous metaplasia, were present at the implantation zone of the tumor. The present case differs from previously reported ones as it was an unexpected finding observed in a non-functioning kidney with good clinical behavior and corresponded to an unusual morphologic variant of osteosarcoma, the telangiectatic type. Finally, the relation with areas of calcification and ossification poses interesting questions as to its histogenenis.
Los sarcomas renales son raros y en ocasiones se relacionan con la cápsula renal o vasos sanguíneos. Dentro de este grupo se han descrito algunos casos de osteosarcoma. En este artículo describimos un caso peculiar de osteosarcoma renal. Un varón de 80 años fue sometido a nefrectomía por estenosis pieloureteral e hidronefrosis. Se observó un tumor hemorrágico adherido a la superficie pielocalicial. Microscópicamente mostró características histológicas propias de osteosarcoma telangiectático. No asociaba áreas de carcinoma urotelial o renal ni otro componente sarcomatoso. Un dato relevante fue la presencia, en la zona de implantación del tumor, de calcificaciones distróficas y focos de osificación heterotópica. El presente caso difiere de los anteriormente publicados. Fue un hallazgo incidental, en un riñón no funcionante, y ha mostrado buen comportamiento clínico. Histológicamente correspondía a la variante telangiectática de osteosarcoma. Por último, la relación con áreas de calcificación y osificación plantea posibles implicaciones histogenéticas.